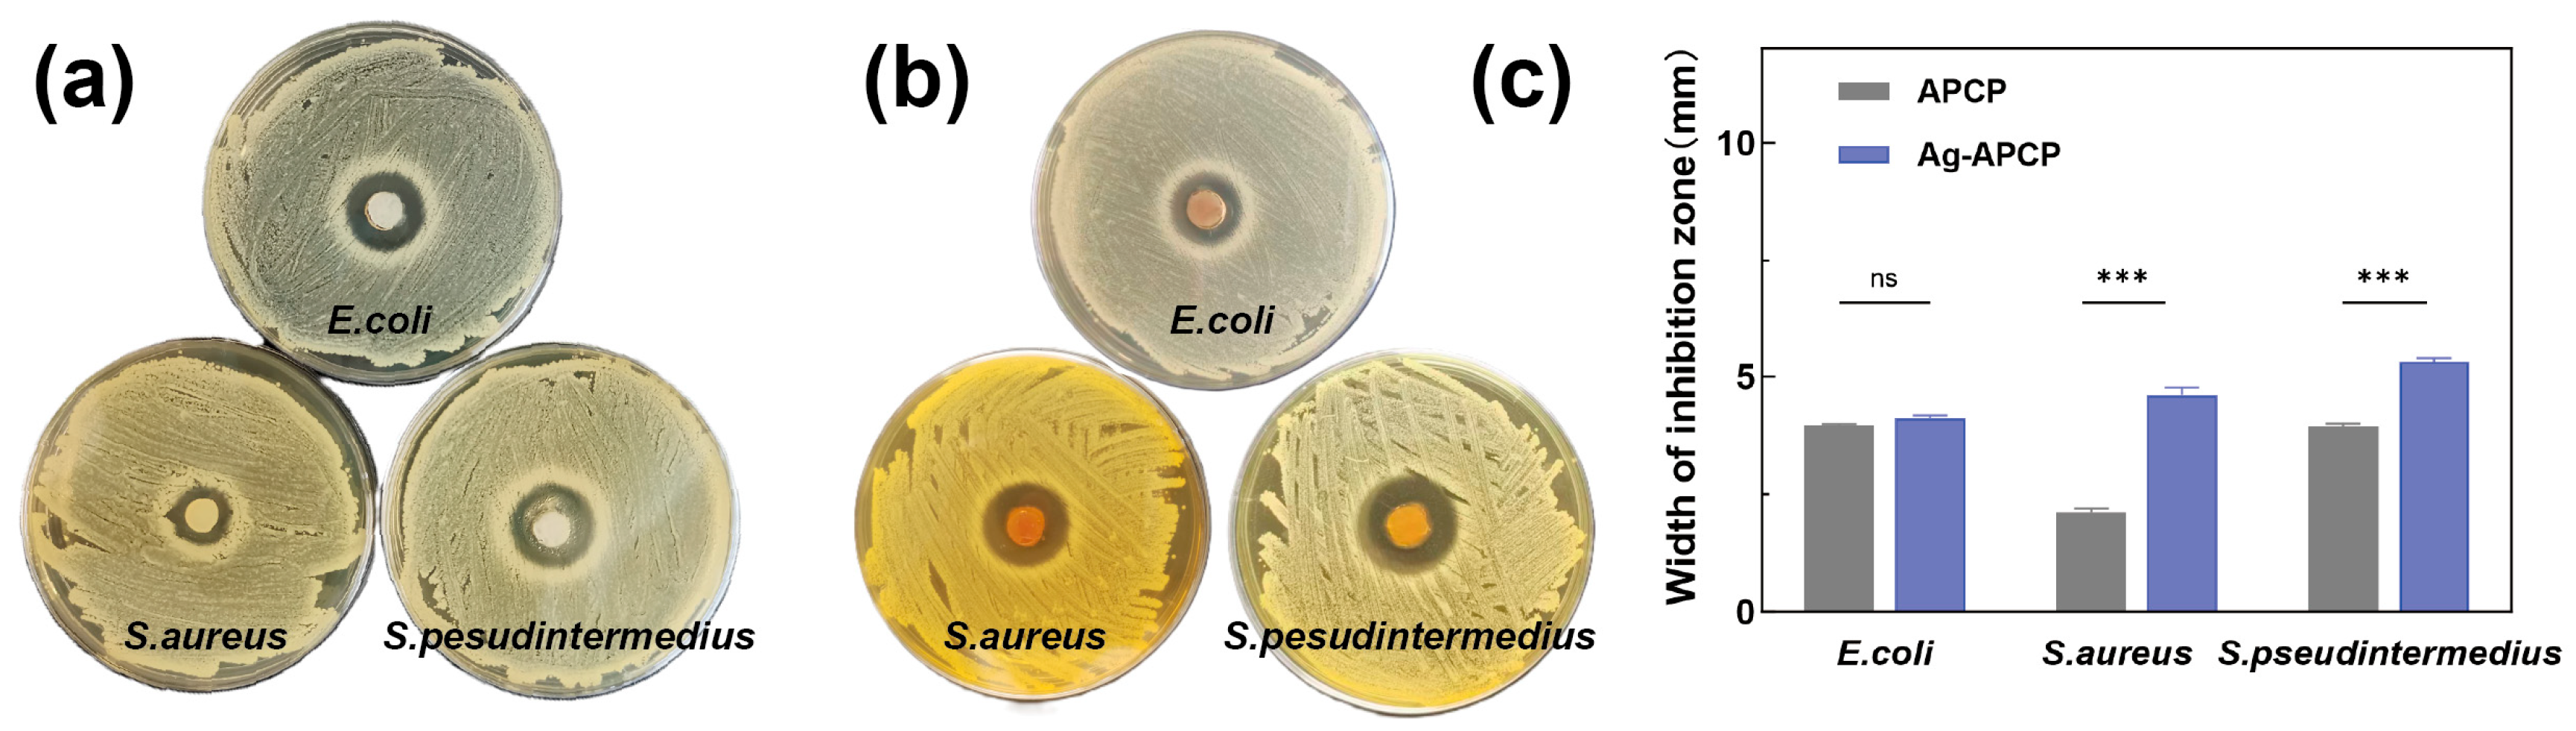

Structural and Gelation Characteristics of Alkali-Soluble β-Glucan from Poria cocos
Abstract
1. Introduction
2. Result and Discussion
2.1. Structural Characterization of APCP
2.1.1. Monosaccharide Composition and Molecular Weight Determination of APCP
2.1.2. The Glycosidic Bond of the APCP
2.2. Preparation and Gelation Conditions of APCP Hydrogel
2.3. Characterization of APCP Hydrogel
2.3.1. Rheology Analysis
2.3.2. Differential Scanning Calorimetry (DSC)
2.3.3. Microstructure
2.4. Molecular Forces
2.5. Macroscopic and Microscopic Evaluation of Ag-APCP Hydrogels
2.6. Swelling Ratios and Water-Holding Capacities
2.7. Antioxidant Activities
2.8. Antibacterial Activity
3. Conclusions
4. Materials and Methods
4.1. Materials and Reagents
4.2. Extraction and Structural Characterization Analysis of Alkali-Soluble Polysaccharides from Poria cocos
4.3. Preparation of APCP Hydrogel
4.4. Rheological Properties
4.5. Characterization of APCP Hydrogel
4.5.1. Scanning Electron Microscope (SEM) Observations
4.5.2. Differential Scanning Calorimetry (DSC) Analysis
4.6. Determination of Molecular Forces
4.7. Synthesis and Morphological Characterization of AgNPs
4.8. Swelling Ratios and Water-Holding Capacities of APCP Hydrogels and Ag-APCP Hydrogels
4.8.1. Swelling Properties
4.8.2. Water Holding Capacity
4.9. Antioxidant Activities of APCP Hydrogels and Ag-APCP Hydrogels
4.10. Antibacterial Activity of APCP Hydrogels and Ag-APCP Hydrogels
4.11. Statistical Analysis
Supplementary Materials
Author Contributions
Funding
Institutional Review Board Statement
Informed Consent Statement
Data Availability Statement
Conflicts of Interest
References
- Fu, K.; Wang, H.; Pan, T.; Cai, Z.; Yang, Z.; Liu, D.; Wang, W. Gel-forming polysaccharides of traditional gel-like foods: Sources, structure, gelling mechanism, and advanced applications. Food Res. Int. 2024, 198, 115329. [Google Scholar] [CrossRef] [PubMed]
- Zhang, S.; Liu, H.; Li, W.; Liu, X.; Ma, L.; Zhao, T.; Ding, Q.; Ding, C.; Liu, W. Polysaccharide-based hydrogel promotes skin wound repair and research progress on its repair mechanism. Int. J. Biol. Macromol. 2023, 248, 125949. [Google Scholar] [CrossRef] [PubMed]
- Manzoor, A.; Dar, A.H.; Pandey, V.K.; Shams, R.; Khan, S.; Panesar, P.S.; Kennedy, J.F.; Fayaz, U.; Khan, S.A. Recent insights into polysaccharide-based hydrogels and their potential applications in food sector: A review. Int. J. Biol. Macromol. 2022, 213, 987–1006. [Google Scholar] [CrossRef] [PubMed]
- Raina, N.; Pahwa, R.; Thakur, V.K.; Gupta, M. Polysaccharide-based hydrogels: New insights and futuristic prospects in wound healing. Int. J. Biol. Macromol. 2022, 223 Pt A, 1586–1603. [Google Scholar] [CrossRef]
- Yuan, N.; Shao, K.; Huang, S.; Chen, C. Chitosan, alginate, hyaluronic acid and other novel multifunctional hydrogel dressings for wound healing: A review. Int. J. Biol. Macromol. 2023, 240, 124321. [Google Scholar] [CrossRef]
- Huang, G.; Huang, S. The structure-activity relationships of natural glucans. Phytother. Res. 2021, 35, 2890–2901. [Google Scholar] [CrossRef]
- Xu, C.; Wang, F.; Guan, S.; Wang, L. β-Glucans obtained from fungus for wound healing: A review. Carbohydr. Polym. 2024, 327, 121662. [Google Scholar] [CrossRef]
- Chen, S.K.; Liu, J.J.; Wang, X.; Luo, H.; He, W.W.; Song, X.X.; Yin, J.Y.; Nie, S.P. Self-assembled near-infrared-photothermal antibacterial Hericium erinaceus β-glucan/tannic acid/Fe (III) hydrogel for accelerating infected wound healing. Carbohydr. Polym. 2025, 348 Pt B, 122898. [Google Scholar] [CrossRef]
- Geng, X.; Zhao, N.; Song, X.; Wu, J.; Zhu, Q.; Wu, T.; Chen, H.; Zhang, M. Fabrication and Characterization of Konjac Glucomannan/Oat β-Glucan Composite Hydrogel: Microstructure, Physicochemical Properties and Gelation Mechanism Studies. Molecules 2022, 27, 8494. [Google Scholar] [CrossRef]
- Zhang, R.; Tao, Y.; Xu, W.; Xiao, S.; Du, S.; Zhou, Y.; Hasan, A. Rheological and controlled release properties of hydrogels based on mushroom hyperbranched polysaccharide and xanthan gum. Int. J. Biol. Macromol. 2018, 120 Pt B, 2399–2409. [Google Scholar] [CrossRef]
- Yang, P.-F.; Hua, T.; Wang, D.; Zhao, Z.-W.; Xi, G.-L.; Chen, Z.-F. Phytochemical and chemotaxonomic study of Poria cocos (schw.) wolf. Biochem. Syst. Ecol. 2019, 83, 54–56. [Google Scholar] [CrossRef]
- Xu, T.; Zhang, H.; Wang, S.; Xiang, Z.; Kong, H.; Xue, Q.; He, M.; Yu, X.; Li, Y.; Sun, D.; et al. A review on the advances in the extraction methods and structure elucidation of Poria cocos polysaccharide and its pharmacological activities and drug carrier applications. Int. J. Biol. Macromol. 2022, 217, 536–551. [Google Scholar] [CrossRef] [PubMed]
- Li, L.; Zuo, Z.T.; Wang, Y.Z. The Traditional Usages, Chemical Components and Pharmacological Activities of Wolfi Poria cocos: A Review. Am. J. Chin. Med. 2022, 50, 389–440. [Google Scholar] [CrossRef] [PubMed]
- Wang, N.; Zhang, Y.; Wang, X.; Huang, X.; Fei, Y.; Yu, Y.; Shou, D. Antioxidant property of water-soluble polysaccharides from Poria cocos Wolf using different extraction methods. Int. J. Biol. Macromol. 2016, 83, 103–110. [Google Scholar] [CrossRef]
- Ng, C.Y.J.; Lai, N.P.Y.; Ng, W.M.; Siah, K.T.H.; Gan, R.-Y.; Zhong, L.L. Chemical structures, extraction and analysis technologies, and bioactivities of edible fungal polysaccharides from Poria cocos: An updated review. Int. J. Biol. Macromol. 2024, 261 Pt 1, 129555. [Google Scholar] [CrossRef]
- Deng, L.; Huang, G. Preparation, structure and application of polysaccharides from Poria cocos. RSC Adv. 2024, 14, 31008–31020. [Google Scholar] [CrossRef]
- Liu, F.; Liu, Y.; Feng, X.; Ibrahim, S.A.; Huang, W. Structure characterization and in vitro immunomodulatory activities of carboxymethyl pachymaran. Int. J. Biol. Macromol. 2021, 178, 94–103. [Google Scholar] [CrossRef]
- Hu, K.; Luo, Q.; Zhu, X.F.; Sun, S.H.; Feng, G.L.; Liu, Z.Y.; Chen, X.M. Isolation of homogeneous polysaccharide from Poria cocos and effect of its sulfated derivatives on migration of human breast cancer MDA-MB-231 cells. China J. Chin. Mater. Med. 2019, 44, 2835–2840. [Google Scholar]
- Xu, L.; Wang, Y.Y.; Huang, J.; Chen, C.Y.; Wang, Z.X.; Xie, H. Silver nanoparticles: Synthesis, medical applications and biosafety. Theranostics 2020, 10, 8996–9031. [Google Scholar] [CrossRef]
- Samuggam, S.V.; Chinni, S.C.B.; Mutusamy, P.; Gopinath, S.; Anbu, P.; Venugopal, V.; Reddy, L.V.; Enugutti, B. Green Synthesis and Characterization of Silver Nanoparticles Using Spondias mombin Extract and Their Antimicrobial Activity against Biofilm-Producing Bacteria. Molecules 2021, 26, 2681. [Google Scholar] [CrossRef]
- Navarro Gallón, S.M.; Alpaslan, E.; Wang, M.; Larese-Casanova, P.; Londoño, M.E.; Atehortúa, L.; Pavón, J.J.; Webster, T.J. Characterization and study of the antibacterial mechanisms of silver nanoparticles prepared with microalgal exopolysaccharides. Mater. Sci. Eng. C Mater. Biol. Appl. 2019, 99, 685–695. [Google Scholar] [CrossRef] [PubMed]
- Nagaraja, S.; Ahmed, S.S.; Goudanavar, P.; Rupesh Kumar, M.; Fattepur, S.; Meravanige, G.; Shariff, A.; Shiroorkar, P.N.; Habeebuddin, M.; Telsang, M. Green Synthesis and Characterization of Silver Nanoparticles of Psidium guajava Leaf Extract and Evaluation for Its Antidiabetic Activity. Molecules 2022, 27, 4336. [Google Scholar] [CrossRef] [PubMed]
- Borchani, C.; Fonteyn, F.; Jamin, G.; Destain, J.; Willems, L.; Paquot, M.; Blecker, C.; Thonart, P. Structural Characterization, Technological Functionality, and Physiological Aspects of Fungal β-D-glucans: A Review. Crit. Rev. Food Sci. Nutr. 2016, 56, 1746–1752. [Google Scholar] [CrossRef]
- Zhou, F.F.; Zhang, Y.D.; Zhang, Q.; Lu, J.; Liu, Y.; Wang, J.H. Structure characterization and immunological activity of a β-glucan from White, H. marmoreus and its silver nanoparticle derivatives. Carbohydr. Polym. 2019, 210, 1–8. [Google Scholar] [CrossRef]
- Abdel-Mohsen, A.M.; Abdel-Rahman, R.M.; Fouda, M.M.; Vojtova, L.; Uhrova, L.; Hassan, A.F.; Al-Deyab, S.S.; El-Shamy, I.E.; Jancar, J. Preparation, characterization and cytotoxicity of schizophyllan/silver nanoparticle composite. Carbohydr. Polym. 2014, 102, 238–245. [Google Scholar] [CrossRef]
- Sun, S.S.; Wang, K.; Ma, K.; Bao, L.; Liu, H.W. An insoluble polysaccharide from the sclerotium of Poria cocos improves hyperglycemia, hyperlipidemia and hepatic steatosis in ob/ob mice via modulation of gut microbiota. Chin. J. Nat. Med. 2019, 17, 3–14. [Google Scholar] [CrossRef]
- Bengoechea, C.; López-Castejón, M.L.; Márquez, S.; Salinas, V.; Puppo, C.; Guerrero, A. Gelation properties of calcium-inulin gels. Food Hydrocoll. 2019, 97, 105239. [Google Scholar] [CrossRef]
- Du, B.; Meenu, M.; Liu, H.; Xu, B. A Concise Review on the Molecular Structure and Function Relationship of β-Glucan. Int. J. Mol. Sci. 2019, 20, 4032. [Google Scholar] [CrossRef]
- Zhao, M.; Guan, Z.; Tang, N.; Cheng, Y. The differences between the water- and alkaline-soluble Poria cocos polysaccharide: A review. Int. J. Biol. Macromol. 2023, 235, 123925. [Google Scholar] [CrossRef]
- Tosif, M.M.; Bains, A.; Sridhar, K.; Dhull, S.B.; Ali, N.; Parvez, M.K.; Chawla, P.; Sharma, M. From plant to nanomaterial: Green extraction of nanomucilage from Cordia dichotoma fruit and its multi-faceted biological and photocatalytic attributes. Int. J. Biol. Macromol. 2024, 282 Pt 1, 136522. [Google Scholar] [CrossRef]
- Dobruchowska, J.M.; Gerwig, G.J.; Kralj, S.; Grijpstra, P.; Leemhuis, H.; Dijkhuizen, L.; Kamerling, J.P. Structural characterization of linear isomalto-/malto-oligomer products synthesized by the novel GTFB 4,6-α-glucanotransferase enzyme from Lactobacillus reuteri 121. Glycobiology 2012, 22, 517–528. [Google Scholar] [CrossRef] [PubMed]
- Kono, H.; Kondo, N.; Hirabayashi, K.; Ogata, M.; Totani, K.; Ikematsu, S.; Osada, M. NMR spectroscopic structural characterization of a water-soluble β-(1→3, 1→6)-glucan from Aureobasidium pullulans. Carbohydr. Polym. 2017, 174, 876–886. [Google Scholar] [CrossRef] [PubMed]
- Li, J.; Gu, F.; Cai, C.; Hu, M.; Fan, L.; Hao, J.; Yu, G. Purification, structural characterization, and immunomodulatory activity of the polysaccharides from Ganoderma lucidum. Int. J. Biol. Macromol. 2020, 143, 806–813. [Google Scholar] [CrossRef]
- Liu, Y.; Zhang, J.; Tang, Q.; Yang, Y.; Guo, Q.; Wang, Q.; Wu, D.; Cui, S.W. Physicochemical characterization of a high molecular weight bioactive β-D-glucan from the fruiting bodies of Ganoderma lucidum. Carbohydr. Polym. 2014, 101, 968–974. [Google Scholar] [CrossRef]
- Synytsya, A.; Novák, M. Structural diversity of fungal glucans. Carbohydr. Polym. 2013, 92, 792–809. [Google Scholar] [CrossRef]
- Jin, Y.; Zhang, L.; Zhang, M.; Chen, L.; Cheung, P.C.; Oi, V.E.; Lin, Y. Antitumor activities of heteropolysaccharides of Poria cocos mycelia from different strains and culture media. Carbohydr. Res. 2003, 338, 1517–1521. [Google Scholar] [CrossRef]
- Chihara, G.; Hamuro, J.; Maeda, Y.; Arai, Y. Antitumor polysaccharides, lentinan and pachymaran. Saishin Igaku. Mod. Med. 1970, 25, 1043–1048. [Google Scholar]
- Sovrani, V.; de Jesus, L.I.; Simas-Tosin, F.F.; Smiderle, F.R.; Iacomini, M. Structural characterization and rheological properties of a gel-like β-d-glucan from Pholiota nameko. Carbohydr. Polym. 2017, 169, 1–8. [Google Scholar] [CrossRef]
- Maniglio, D.; Bissoli, E.; Callone, E.; Dirè, S.; Motta, A. Polymeric Hydrogels for Intervertebral Disc Replacement/Integration: Playing with the Chemical Composition for Tuning Shear Behavior and Hydrophilicity. Gels 2023, 9, 912. [Google Scholar] [CrossRef]
- Ghilan, A.; Nita, L.E.; Pamfil, D.; Simionescu, N.; Tudorachi, N.; Rusu, D.; Rusu, A.G.; Bercea, M.; Rosca, I.; Ciolacu, D.E.; et al. One-Step Preparation of Carboxymethyl Cellulose-Phytic Acid Hydrogels with Potential for Biomedical Applications. Gels 2022, 8, 647. [Google Scholar] [CrossRef]
- Zhang, T.; Wang, Z.; Yu, S.; Guo, X.; Meng, H. Effects of pH and temperature on the structure, rheological and gel-forming properties of sugar beet pectins. Food Hydrocoll. 2021, 116, 106646. [Google Scholar] [CrossRef]
- Chen, Y.; Song, L.; Chen, P.; Liu, H.; Zhang, X. Extraction, Rheological, and Physicochemical Properties of Water-Soluble Polysaccharides with Antioxidant Capacity from Penthorum chinense Pursh. Foods 2023, 12, 2335. [Google Scholar] [CrossRef] [PubMed]
- Chen, M.; Hu, Z.; Zheng, H.; Wang, J.; Xu, X. Antimicrobial polysaccharide hydrogels embedded with methyl-β-cyclodextrin/thyme oil inclusion complexes for exceptional mechanical performance and chilled chicken breast preservation. Int. J. Biol. Macromol. 2024, 267 Pt 2, 131586. [Google Scholar] [CrossRef]
- Ajvazi, N.; Milošev, I.; Cerc Korošec, R.; Rodič, P.; Božić, B. Development and Characterization of Gelatin-Based Hydrogels Containing Triblock Copolymer and Phytic Acid. Gels 2024, 10, 294. [Google Scholar] [CrossRef]
- Lv, D.; Chen, F.; Yang, X.; Yin, L.; Rashid, M.T.; Li, Y. Spontaneous gelation behaviors and mechanism of Ficus awkeotsang Makino pectin. Int. J. Biol. Macromol. 2023, 247, 125712. [Google Scholar] [CrossRef]
- Zhao, L.; Li, J.; Ding, Y.; Sun, L. Preparation and Characterization of a Novel Longzhua mushroom Polysaccharide Hydrogel and Slow-Release Behavior of Encapsulated Rambutan Peel Polyphenols. Foods 2024, 13, 1711. [Google Scholar] [CrossRef]
- Wang, Y.; Yang, M.; Zhao, Z. Facile fabrication of self-healing, injectable and antimicrobial cationic guar gum hydrogel dressings driven by hydrogen bonds. Carbohydr. Polym. 2023, 310, 120723. [Google Scholar] [CrossRef]
- Yang, X.; Guo, C.; Yang, Y.; Yuan, K.; Yang, X.; Guo, Y. Rheological and gelling properties of Nicandra physalodes (Linn.) Gaertn. pectin in acidic media. Food Chem. 2022, 373, 131711. [Google Scholar] [CrossRef]
- Wang, W.; Shen, M.; Liu, S.; Jiang, L.; Song, Q.; Xie, J. Gel properties and interactions of Mesona blumes polysaccharide-soy protein isolates mixed gel: The effect of salt addition. Carbohydr. Polym. 2018, 192, 193–201. [Google Scholar] [CrossRef]
- Wang, W.; Jiang, L.; Ren, Y.; Shen, M.; Xie, J. Gelling mechanism and interactions of polysaccharides from Mesona blumes: Role of urea and calcium ions. Carbohydr. Polym. 2019, 212, 270–276. [Google Scholar] [CrossRef]
- Du, Q.; Zhou, L.; Lyu, F.; Liu, J.; Ding, Y. The complex of whey protein and pectin: Interactions, functional properties and applications in food colloidal systems—A review. Colloids Surf. B Biointerfaces 2022, 210, 112253. [Google Scholar] [CrossRef] [PubMed]
- Ahmad, S.; Munir, S.; Zeb, N.; Ullah, A.; Khan, B.; Ali, J.; Bilal, M.; Omer, M.; Alamzeb, M.; Salman, S.M.; et al. Green nanotechnology: A review on green synthesis of silver nanoparticles—An ecofriendly approach. Int. J. Nanomed. 2019, 14, 5087–5107. [Google Scholar] [CrossRef] [PubMed]
- Zhang, X.F.; Liu, Z.G.; Shen, W.; Gurunathan, S. Silver Nanoparticles: Synthesis, Characterization, Properties, Applications, and Therapeutic Approaches. Int. J. Mol. Sci. 2016, 17, 1534. [Google Scholar] [CrossRef]
- Djafarou, R.; Brahmia, O.; Haya, S.; Sahmetlioglu, E.; Kılıç Dokan, F.; Hidouri, T. Starch-Assisted Eco-Friendly Synthesis of ZnO Nanoparticles: Enhanced Photocatalytic, Supercapacitive, and UV-Driven Antioxidant Properties with Low Cytotoxic Effects. Int. J. Mol. Sci. 2025, 26, 859. [Google Scholar] [CrossRef]
- Habeeb Rahuman, H.B.; Dhandapani, R.; Narayanan, S.; Palanivel, V.; Paramasivam, R.; Subbarayalu, R.; Thangavelu, S.; Muthupandian, S. Medicinal plants mediated the green synthesis of silver nanoparticles and their biomedical applications. IET Nanobiotechnol. 2022, 16, 115–144. [Google Scholar] [CrossRef]
- Mousavi, S.M.; Hashemi, S.A.; Ghasemi, Y.; Atapour, A.; Amani, A.M.; Savar Dashtaki, A.; Babapoor, A.; Arjmand, O. Green synthesis of silver nanoparticles toward bio and medical applications: Review study. Artif. Cells Nanomed. Biotechnol. 2018, 46 (Suppl. S3), S855–S872. [Google Scholar] [CrossRef]
- Jia, X.; Yao, Y.; Yu, G.; Qu, L.; Li, T.; Li, Z.; Xu, C. Synthesis of gold-silver nanoalloys under microwave-assisted irradiation by deposition of silver on gold nanoclusters/triple helix glucan and antifungal activity. Carbohydr. Polym. 2020, 238, 116169. [Google Scholar] [CrossRef]
- Jiang, Y.; Huang, J.; Wu, X.; Ren, Y.; Li, Z.; Ren, J. Controlled release of silver ions from AgNPs using a hydrogel based on konjac glucomannan and chitosan for infected wounds. Int. J. Biol. Macromol. 2020, 149, 148–157. [Google Scholar] [CrossRef]
- Wang, S.H.; Yang, W.B.; Liu, Y.C.; Chiu, Y.H.; Chen, C.T.; Kao, P.F.; Lin, C.M. A potent sphingomyelinase inhibitor from Cordyceps mycelia contributes its cytoprotective effect against oxidative stress in macrophages. J. Lipid Res. 2011, 52, 471–479. [Google Scholar] [CrossRef]
- Liu, X.; Huang, L.; Zhang, X.; Xu, X. Polysaccharides with antioxidant activity: Extraction, beneficial roles, biological mechanisms, structure-function relationships, and future perspectives: A review. Int. J. Biol. Macromol. 2025, 300, 140221. [Google Scholar] [CrossRef]
- Singh, R.; Shedbalkar, U.U.; Wadhwani, S.A.; Chopade, B.A. Bacteriagenic silver nanoparticles: Synthesis, mechanism, and applications. Appl. Microbiol. Biotechnol. 2015, 99, 4579–4593. [Google Scholar] [CrossRef] [PubMed]
- Chen, N.; Jiang, T.; Xu, J.; Xi, W.; Shang, E.; Xiao, P.; Duan, J.A. The relationship between polysaccharide structure and its antioxidant activity needs to be systematically elucidated. Int. J. Biol. Macromol. 2024, 270 Pt 2, 132391. [Google Scholar] [CrossRef] [PubMed]
- Irshad, A.; Sarwar, N.; Sadia, H.; Malik, K.; Javed, I.; Irshad, A.; Afzal, M.; Abbas, M.; Rizvi, H. Comprehensive facts on dynamic antimicrobial properties of polysaccharides and biomolecules-silver nanoparticle conjugate. Int. J. Biol. Macromol. 2020, 145, 189–196. [Google Scholar] [CrossRef]
- Badshah, H.; Qureshi, R.A.; Khan, J.; Ullah, F.; Khan, N. Pharmacological screening of Morchella esculenta (L.) Pers. Calvatia gigantea (Batsch ex Pers.) Lloyd and Astraeus hygrometricus Pers. mushroom collected from South Waziristan (FATA.). J. Med. Plant Res. 2012, 6, 1853–1859. [Google Scholar]
- Naganthran, A.; Verasoundarapandian, G.; Khalid, F.E.; Masarudin, M.J.; Zulkharnain, A.; Nawawi, N.M.; Karim, M.; Che Abdullah, C.A.; Ahmad, S.A. Synthesis, Characterization and Biomedical Application of Silver Nanoparticles. Materials 2022, 15, 427. [Google Scholar] [CrossRef]
- Al-Dbass, A.M.; Daihan, S.A.; Al-Nasser, A.A.; Al-Suhaibani, L.S.; Almusallam, J.; Alnwisser, B.I.; Saloum, S.; Alotaibi, R.S.; Alessa, L.A.; Bhat, R.S. Biogenic Silver Nanoparticles from Two Varieties of Agaricus bisporus and Their Antibacterial Activity. Molecules 2022, 27, 7656. [Google Scholar] [CrossRef]
- Moses, I.B.; Santos, F.F.; Gales, A.C. Human Colonization and Infection by Staphylococcus pseudintermedius: An Emerging and Underestimated Zoonotic Pathogen. Microorganisms 2023, 11, 581. [Google Scholar] [CrossRef]
- Ferrer, L.; García-Fonticoba, R.; Pérez, D.; Viñes, J.; Fàbregas, N.; Madroñero, S.; Meroni, G.; Martino, P.A.; Martínez, S.; Maté, M.L.; et al. Whole genome sequencing and de novo assembly of Staphylococcus pseudintermedius: A pangenome approach to unravelling pathogenesis of canine pyoderma. Vet. Dermatol. 2021, 32, 654–663. [Google Scholar] [CrossRef]
- Fàbregas, N.; Pérez, D.; Viñes, J.; Cuscó, A.; Migura-García, L.; Ferrer, L.; Francino, O. Diverse Populations of Staphylococcus pseudintermedius Colonize the Skin of Healthy Dogs. Microbiol. Spectr. 2023, 11, e0339322. [Google Scholar] [CrossRef]
- Suepaul, S.; Stegger, M.; Boyen, F.; Georges, K.; Butaye, P. The Diversity and Zoonotic Potential of Staphylococcus pseudintermedius in Humans and Pet Dogs in Trinidad and Tobago. Antibiotics 2023, 12, 1266. [Google Scholar] [CrossRef]
- Roberts, E.; Nuttall, T.J.; Gkekas, G.; Mellanby, R.J.; Fitzgerald, J.R.; Paterson, G.K. Not just in man’s best friend: A review of Staphylococcus pseudintermedius host range and human zoonosis. Res. Vet. Sci. 2024, 174, 105305. [Google Scholar] [CrossRef] [PubMed]
- Lozano, C.; Rezusta, A.; Ferrer, I.; Pérez-Laguna, V.; Zarazaga, M.; Ruiz-Ripa, L.; Revillo, M.J.; Torres, C. Staphylococcus pseudintermedius Human Infection Cases in Spain: Dog-to-Human Transmission. Vector Borne Zoonotic Dis. 2017, 17, 268–270. [Google Scholar] [CrossRef] [PubMed]
- Pires Dos Santos, T.; Damborg, P.; Moodley, A.; Guardabassi, L. Systematic Review on Global Epidemiology of Methicillin-Resistant Staphylococcus pseudintermedius: Inference of Population Structure from Multilocus Sequence Typing Data. Front. Microbiol. 2016, 7, 1599. [Google Scholar] [CrossRef]
- Nocera, F.P.; De Martino, L. Methicillin-resistant Staphylococcus pseudintermedius: Epidemiological changes, antibiotic resistance, and alternative therapeutic strategies. Vet. Res. Commun. 2024, 48, 3505–3515. [Google Scholar] [CrossRef]
- Wang, Y.; Mo, Q.; Li, Z.; Lai, H.; Lou, J.; Liu, S.; Mao, J. Effects of degree of carboxymethylation on physicochemical and biological properties of pachyman. Int. J. Biol. Macromol. 2012, 51, 1052–1056. [Google Scholar] [CrossRef]
- Li, W.; Fang, K.; Yuan, H.; Li, D.; Li, H.; Chen, Y.; Luo, X.; Zhang, L.; Ye, X. Acid-induced Poria cocos alkali-soluble polysaccharide hydrogel: Gelation behaviour, characteristics, and potential application in drug delivery. Int. J. Biol. Macromol. 2023, 242 Pt 2, 124383. [Google Scholar] [CrossRef]
- Hu, C.; Lu, W.; Sun, C.; Zhao, Y.; Zhang, Y.; Fang, Y. Gelation behavior and mechanism of alginate with calcium: Dependence on monovalent counterions. Carbohydr. Polym. 2022, 294, 119788. [Google Scholar] [CrossRef]
- Ma, Q.; Xu, Q.; Chen, N.; Zeng, W. Gel properties of Nicandra physalodes (Linn.) gaertn. seeds polysaccharides with tea polyphenols and its application. Food Chem. X 2024, 23, 101707. [Google Scholar] [CrossRef]
- Jiang, W.X.; Qi, J.R.; Liao, J.S.; Yang, X.Q. Acid/ethanol induced pectin gelling and its application in emulsion gel. Food Hydrocoll. 2021, 118, 106774. [Google Scholar] [CrossRef]

| APCP | Man (%) | Glc (%) | Mw (kDa) | Mn (kDa) | Mw/Mn |
| 0.10% | 99.896 | 314.2 | 237.4 | 1.32 |
| Glycosidic Linkage | PMAA | Retention Time (min) | Molar Fraction (%) |
|---|---|---|---|
| t-Glc(p) | 1,5-di-O-acetyl-2,3,4,6-tetra-O-methyl glucitol | 16.809 | 12.272 |
| 3-Glc(p) | 1,4,5-tri-O-acetyl-2,3,6-tri-O-methyl glucitol | 19.827 | 77.497 |
| 3,4-Glc(p) | 1,3,4,5-tetra-O-acetyl-2,6-di-O-methyl glucitol | 22.018 | 1.244 |
| 2,3-Glc(p) | 1,2,3,5-tetra-O-acetyl-4,6-di-O-methyl glucitol | 22.349 | 4.018 |
| 3,6-Glc(p) | 1,3,5,6-tetra-O-acetyl-2,4-di-O-methyl glucitol | 23.483 | 4.970 |
| Residue | Chemical Shift (ppm) | ||||||||
|---|---|---|---|---|---|---|---|---|---|
| 1 | 2 | 3 | 4 | 5 | 6a | 6b | |||
| G3 | →3)-β-D-Glcp-(1→ | H | 4.71 | 3.47 | 3.7 | 3.43 | 3.43 | 3.66 | 3.84 |
| C | 102.46 | 73.08 | 84.1 | 67.88 | 75.5 | 60.45 | |||
| G36 | →3,6)-β-D-Glcp-(1→ | H | 4.72 | 3.46 | 3.71 | 3.45 | 3.44 | -- | -- |
| C | 102.37 | 73.09 | 84.12 | 67.97 | 75.44 | -- | |||
| Gt | β-D-Glcp-(1→ | H | 4.67 | 3.26 | 3.45 | 3.33 | 3.39 | 3.65 | 3.84 |
| C | 102.52 | 73.28 | 75.55 | 69.53 | 75.5 | 60.41 | |||
| Rα | →3)-α-D-Glcp | H | 5.14 | 3.62 | 3.83 | 3.40 | 3.78 | 3.74 | 3.79 |
| C | 91.79 | 70.91 | 82.02 | 69.44 | 71.00 | 60.35 | |||
| Rβ | →3)-β-D-Glcp | H | 4.59 | 3.34 | 3.46 | 3.44 | 3.32 | 3.64 | 3.80 |
| C | 95.65 | 73.80 | 83.78 | 67.92 | 75.73 | 60.42 | |||
Disclaimer/Publisher’s Note: The statements, opinions and data contained in all publications are solely those of the individual author(s) and contributor(s) and not of MDPI and/or the editor(s). MDPI and/or the editor(s) disclaim responsibility for any injury to people or property resulting from any ideas, methods, instructions or products referred to in the content. |
© 2025 by the authors. Licensee MDPI, Basel, Switzerland. This article is an open access article distributed under the terms and conditions of the Creative Commons Attribution (CC BY) license (https://creativecommons.org/licenses/by/4.0/).
Share and Cite
Li, Z.; Sun, C.; Wang, F.; Xia, Z. Structural and Gelation Characteristics of Alkali-Soluble β-Glucan from Poria cocos. Gels 2025, 11, 387. https://doi.org/10.3390/gels11060387
Li Z, Sun C, Wang F, Xia Z. Structural and Gelation Characteristics of Alkali-Soluble β-Glucan from Poria cocos. Gels. 2025; 11(6):387. https://doi.org/10.3390/gels11060387
Chicago/Turabian StyleLi, Zhixing, Chenglei Sun, Fan Wang, and Zhaofei Xia. 2025. "Structural and Gelation Characteristics of Alkali-Soluble β-Glucan from Poria cocos" Gels 11, no. 6: 387. https://doi.org/10.3390/gels11060387
APA StyleLi, Z., Sun, C., Wang, F., & Xia, Z. (2025). Structural and Gelation Characteristics of Alkali-Soluble β-Glucan from Poria cocos. Gels, 11(6), 387. https://doi.org/10.3390/gels11060387

